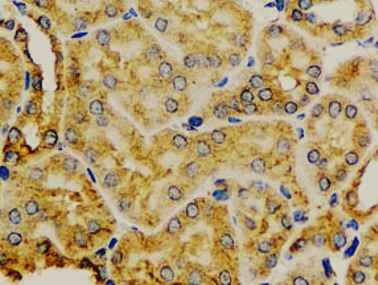
Anti-MYLK

Cookie preferences
This website uses cookies, which are necessary for the technical operation of the website and are always set. Other cookies, which increase the comfort when using this website, are used for direct advertising or to facilitate interaction with other websites and social networks, are only set with your consent.
Configuration
Technically required
These cookies are necessary for the basic functions of the shop.
"Allow all cookies" cookie
"Decline all cookies" cookie
CSRF token
Cookie preferences
Currency change
Customer-specific caching
FACT-Finder tracking
Individual prices
Selected shop
Session
Comfort functions
These cookies are used to make the shopping experience even more appealing, for example for the recognition of the visitor.
Note
Show the facebook fanpage in the right blod sidebar
Statistics & Tracking
Affiliate program
Conversion and usertracking via Google Tag Manager
Track device being used
| Item number | Size | Datasheet | Manual | SDS | Delivery time | Quantity | Price |
|---|---|---|---|---|---|---|---|
| ARG56412.100 | 100 µl | - | - |
6 - 14 business days* |
707.00€
|
If you have any questions, please use our Contact Form.
You can also order by e-mail: info@biomol.com
Larger quantity required? Request bulk
You can also order by e-mail: info@biomol.com
Larger quantity required? Request bulk
Protein function: Calcium/calmodulin-dependent myosin light chain kinase implicated in smooth... more
Product information "Anti-MYLK"
Protein function: Calcium/calmodulin-dependent myosin light chain kinase implicated in smooth muscle contraction via phosphorylation of myosin light chains (MLC). Also regulates actin-myosin interaction through a non-kinase activity. Phosphorylates PTK2B/PYK2 and myosin light-chains. Involved in the inflammatory response (e.g. apoptosis, vascular permeability, leukocyte diapedesis), cell motility and morphology, airway hyperreactivity and other activities relevant to asthma. Required for tonic airway smooth muscle contraction that is necessary for physiological and asthmatic airway resistance. Necessary for gastrointestinal motility. Implicated in the regulation of endothelial as well as vascular permeability, probably via the regulation of cytoskeletal rearrangements. In the nervous system it has been shown to control the growth initiation of astrocytic processes in culture and to participate in transmitter release at synapses formed between cultured sympathetic ganglion cells. Critical participant in signaling sequences that result in fibroblast apoptosis. Plays a role in the regulation of epithelial cell survival. Required for epithelial wound healing, especially during actomyosin ring contraction during purse-string wound closure. Mediates RhoA- dependent membrane blebbing. Triggers TRPC5 channel activity in a calcium-dependent signaling, by inducing its subcellular localization at the plasma membrane. Promotes cell migration (including tumor cells) and tumor metastasis. PTK2B/PYK2 activation by phosphorylation mediates ITGB2 activation and is thus essential to trigger neutrophil transmigration during acute lung injury (ALI). May regulate optic nerve head astrocyte migration. Probably involved in mitotic cytoskeletal regulation. Regulates tight junction probably by modulating ZO-1 exchange in the perijunctional actomyosin ring. Mediates burn-induced microvascular barrier injury, triggers endothelial contraction in the development of microvascular hyperpermeability by phosphorylating MLC. Essential for intestinal barrier dysfunction. Mediates Giardia spp.-mediated reduced epithelial barrier function during giardiasis intestinal infection via reorganization of cytoskeletal F-actin and tight junctional ZO-1. Necessary for hypotonicity-induced Ca(2+) entry and subsequent activation of volume-sensitive organic osmolyte/anion channels (VSOAC) in cervical cancer cells. Responsible for high proliferative ability of breast cancer cells through anti-apoptosis. [The UniProt Consortium]
| Keywords: | Anti-MLCK, Anti-MYLK, EC=2.7.11.18 |
| Supplier: | Arigo Biolaboratories |
| Supplier-Nr: | ARG56412 |
Properties
| Application: | WB, IHC (paraffin) |
| Antibody Type: | Polyclonal |
| Conjugate: | No |
| Host: | Rabbit |
| Species reactivity: | human, mouse, rat |
| Immunogen: | Recombinant protein of Human MYLK |
| Format: | Antigen Affinity Purified |
Database Information
| KEGG ID : | K00907 | Matching products |
| UniProt ID : | Q15746 | Matching products |
| Gene ID : | GeneID 4638 | Matching products |
Handling & Safety
| Storage: | -20°C |
| Shipping: | +4°C (International: +4°C) |
Caution
Our products are for laboratory research use only: Not for administration to humans!
Our products are for laboratory research use only: Not for administration to humans!
Information about the product reference will follow.
more
You will get a certificate here
Viewed